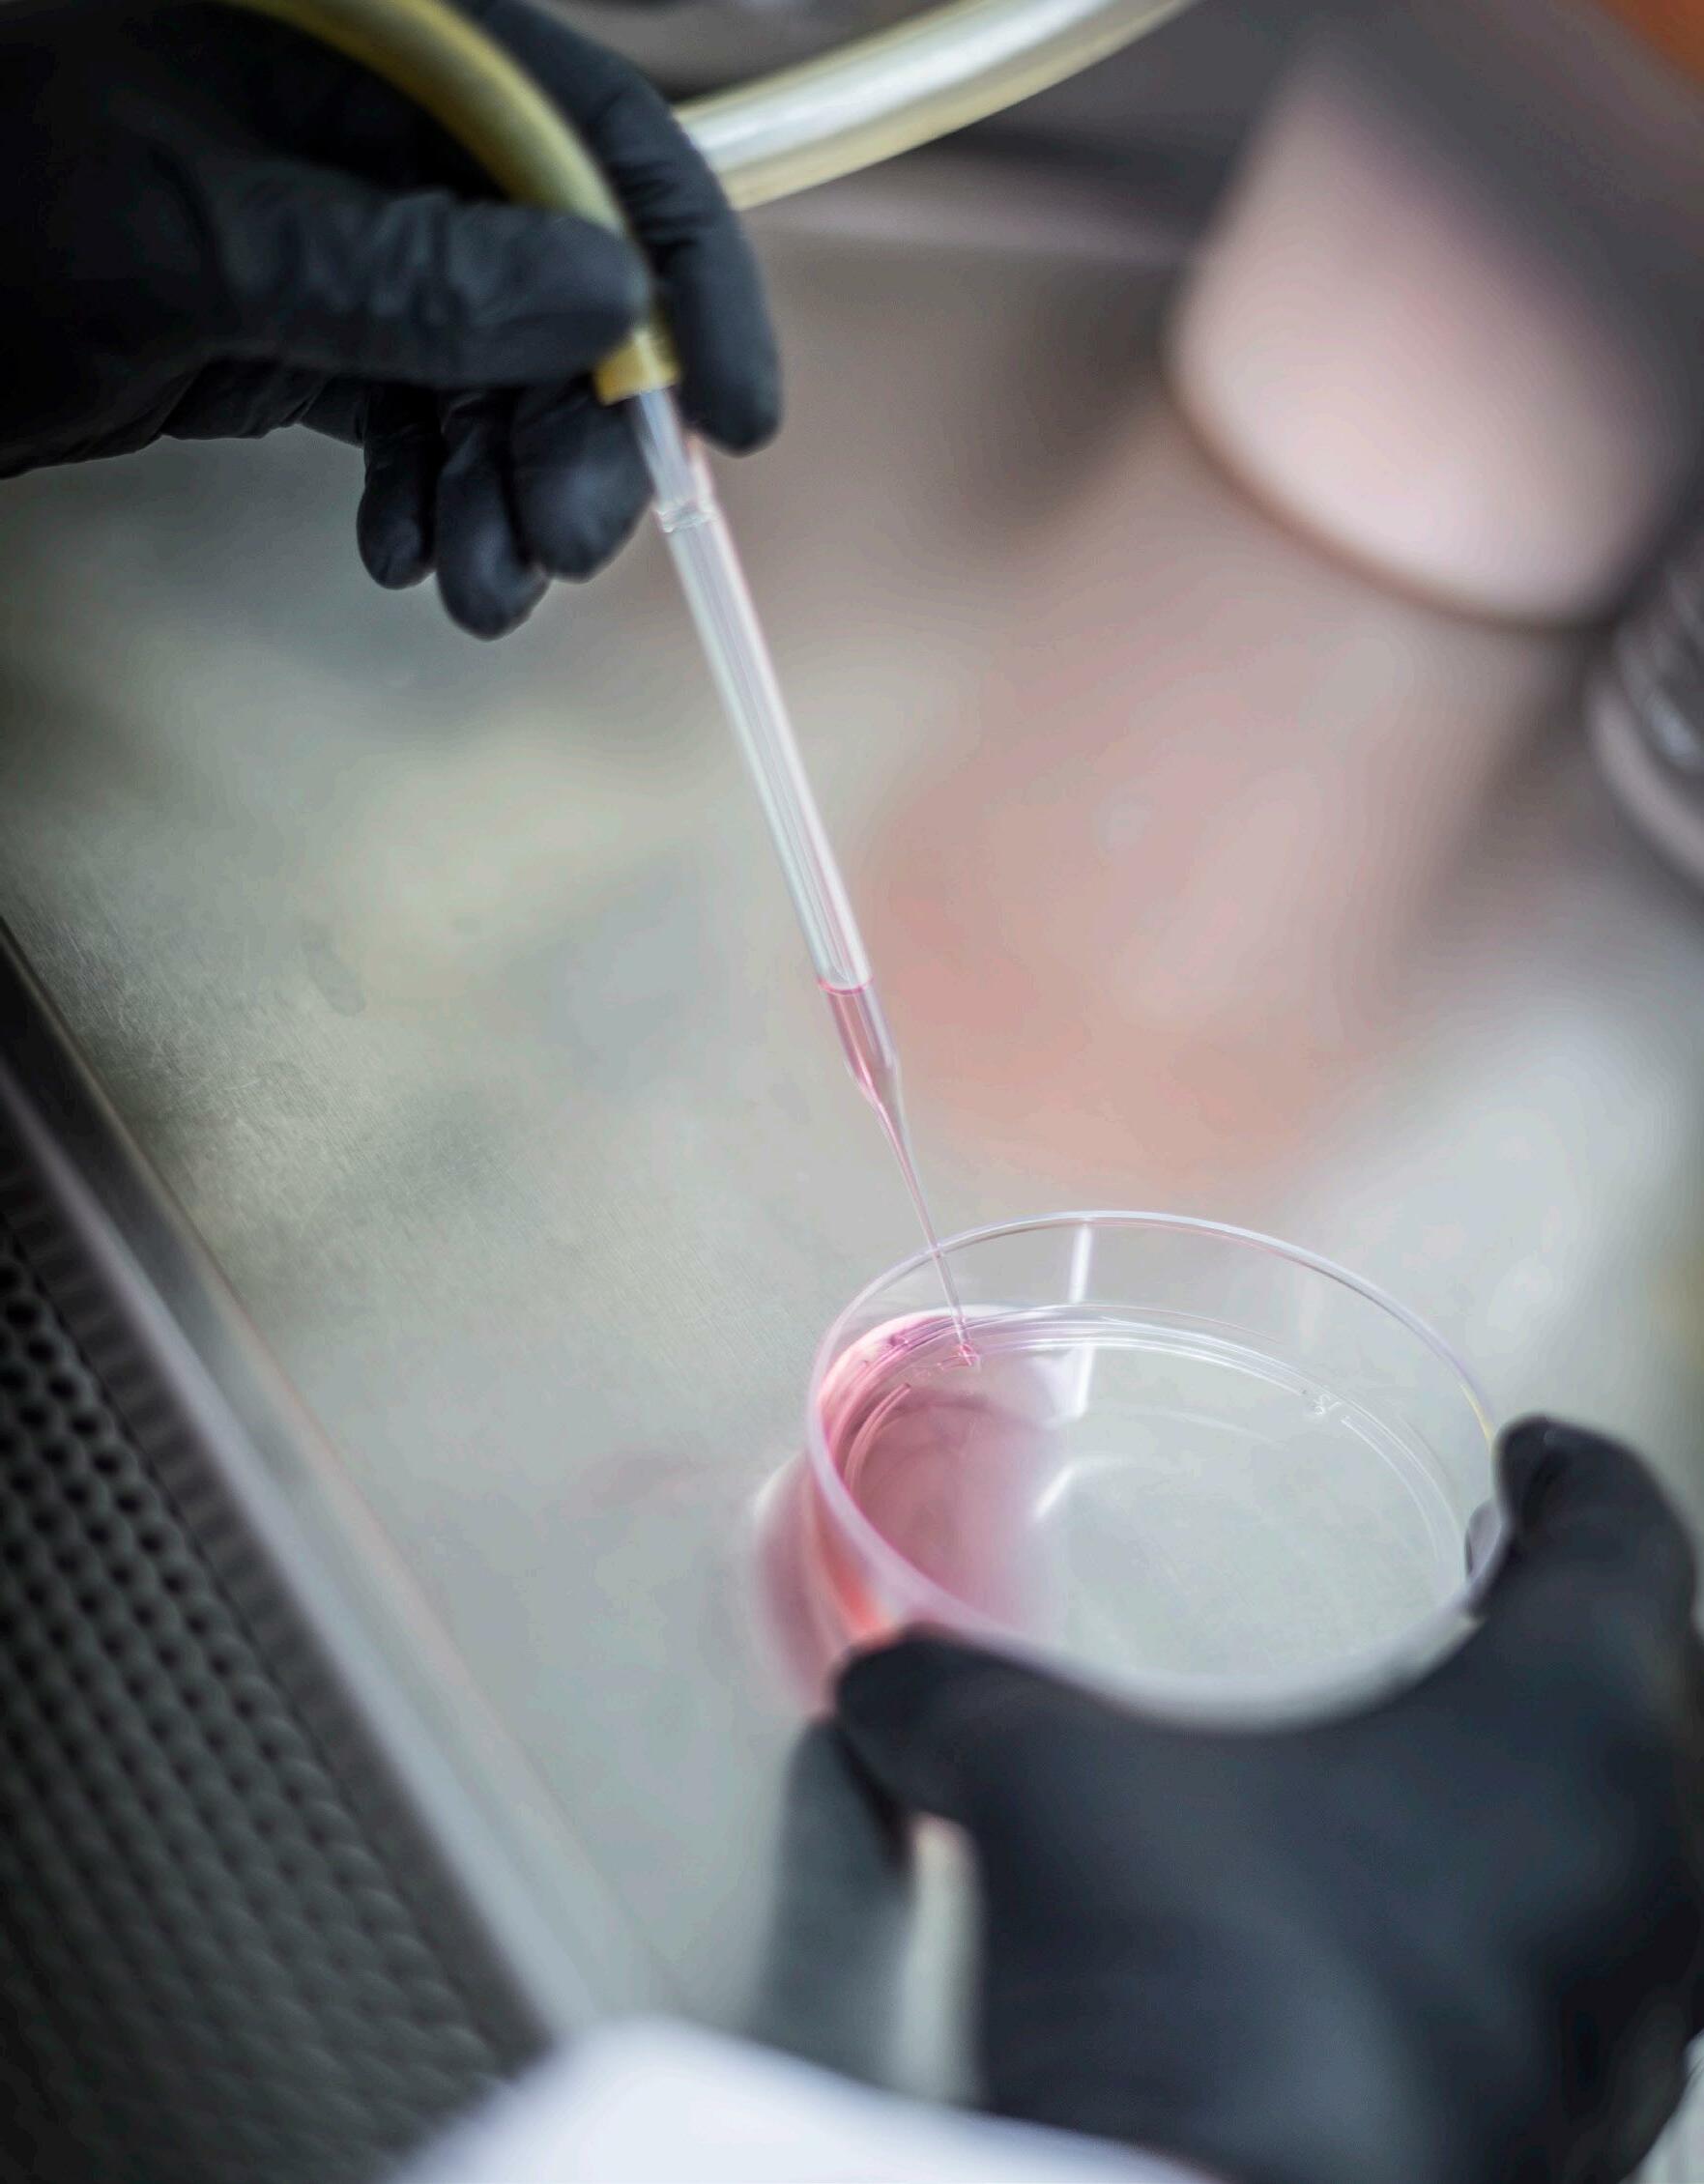

DOCTOR OF PHILOSOPHY (PhD)


Nursing


Caring Diversity Integrity Leadership CORE VALUES


TABLE OF CONTENTS 2 WELCOME TO LOEWENBERG COLLEGE OF NURSING 3 PROGRAM OUTCOMES 4 HEALTH EQUITY RESEARCH MODEL 6 PhD STUDENT TESTIMONIALS 7 FACULTY RESEARCH INTERESTS 8 ADMISSION CRITERIA 9 POST-MASTERS CURRICULUM 11 POST-DNP CURRICULUM 13 MISSION, VISION, STRATEGIC GOALS
Welcome to the Loewenberg College of Nursing (LCON)!
The faculty and staff at LCON thank you for considering our PhD program.
Faculty will mentor and guide you to become a nurse scientist, an educator and/ or a nurse leader. We work together in a culture of scholarly inquiry that cultivates curiosity and creativity to advance nursing knowledge that makes a healthy impact on people, the community and healthcare.


Sincerely,
LCON Faculty and Staff
2
The PhD program in Nursing offered by the University of Memphis Loewenberg College of Nursing is a terminal research degree that prepares nurses to conduct research in academic nursing and healthcare settings. The PhD program is designed for those who plan to assume roles in nursing academics and practice settings using research experimentation and theory application to generate new nursing knowledge and transform healthcare.
Program Outcomes
Graduates of the PhD program will be prepared to:
1. Conduct nursing and interdisciplinary research,
2. Generate new knowledge that guides nursing practice and
3. Lead educational research in program and course design, clinical education and the evaluation of learning that prepares nurses of the future.
Graduates will be prepared as nurse scientists to generate and translate knowledge toward improving the health and health equity of individuals, families, communities and populations.

3
Faculty in Nursing and at the UofM have a variety of research backgrounds and conduct research in several areas centered around the theme Health Equity Research. The Health Equity Research Model details how each focus area distinctly highlights the correlation of these concepts in the PhD program.

4
Health Equity Framework

Reference: Healthy People 2020: Social Determination of Health; Health Disparities and Health Equity
Social Conditions Environmental Conditions Economic Conditions Access & Affordability to Quality Health Care Disease, Injury Health Behaviors Health Policy Quality of Life Mortality/Life Expectancy 5
PhD Student Testimonials
Tracie Moore
“Being a PhD student at LCON is an extraordinary experience. I enjoy the course content, teamwork culture and even the homework. I believe this will be the challenging but rewarding season of my life.”

Feifei Gu
Nursing Department Professor, School of International Medical Technology Shanghai Sanda University
“This has been a rewarding experience thus far. The professors have been excellent at cultivating the nurse scientists in us. I look forward to what the rest of the program brings!”
CEO/Owner of Moorehealthcare and ER Nurse
6
Faculty Research Areas


• Health Promotion across the Lifespan • Achieving Health Equity - Reducing Health Disparities - Vulnerable Populations - LGBTQ • Health Behaviors in Women, Children and Older Adults • Quality of Life – Older adults, End of Life and Palliative Care • Managed Care – Cardiovascular Health, Acute Coronary Syndrome and Patient Experiences • Building a Culture of Health for Urban Children and Families • Health Literacy • Health Policy • Technology – Telehealth, Simulation, Virtual Reality • Education Research — Diversity, Retention, Leadership and Mentoring 77
Admissions Criteria
The applicant must meet all criteria for admission to the Graduate School. A master’s degree is required for admission and international applicants will be expected to submit a minimum score of 550 on the paper, a 210 on the computer-based or 79 on the Internet Based Test of English as a Foreign Language (TOEFL).
Additionally, applicants will:
1. Possess an unencumbered RN license or equivalent in the student’s state/nation of residence.
2. Have earned a BSN, master’s degree in Nursing or DNP with minimum GPA of 3.0. If a GPA is not available, the Graduate Record Examination (GRE) is required with scores from the last five years with a minimum of verbal and quantitative score of 140 and analytical writing score of at least 3.0.
3. Provide three letters of reference from individuals familiar with the applicant’s capabilities for doctoral study and for future performance as a nurse scholar and researcher. Generally, two letters from former professors will be expected.
4. Submit a personal statement of approximately 750-1000 words indicating his/her present interests and career goals, including how the PhD in Nursing will prepare the student to achieve those goals.
5. Provide a writing samle (e.g., published paper or coursework from previous degree program is acceptable).
6. Provide a copy of the applicant’s curriculum vitae (CV) or resume.
7. An interview via phone, face-to-face or Zoom will be required.
The PhD Program Committee will review all submitted materials. Admissions decisions are made on the overall quality of the applicant’s professional background in nursing, scholarship and academic ability, as well as the applicant’s “fit” for the program in terms of academic background, research interests and career goals.
Academic Success
The PhD Program curriculum is designed with several core areas: Nursing Science, Research, Health Equity Research, Elective and Dissertation. LCON offers three pathways for qualified applicants to earn the PhD nursing degree: Post BSN to PhD, Post MSN to PhD and Post DNP to PhD.
8
PhD Curriculum | Post-MSN Sample Plan of Study YEAR 1 Spring Summer Fall NURS 8111 Philosophy of Science 3 ICL 8003 Curriculum Design and Evaluation 3 NURS 8113 Health Equity Research 3 NURS 8112 Middle Range Theories in Nursing and Health Equity 3 NURS 8213 Quantitative Methods 3 NURS 8313 Responsible Conduct of Research 1 Total 6 Total 3 Total 7 YEAR 2 Spring Summer Fall NURS 8211 Qualitative Methods 3 EDPR 8541 Statistical Methods and Apps in Education 3 PUBH 7150 Biostatistical Methods I 3 PUBH 7160 Social and Behavioral Science Principles 3 Elective 3 NURS 8312 Doctoral Research Seminar II 3 NURS 8311 Doctoral Research Seminar I 3 Elective 3 Total 9 Total 6 Total 9 YEAR 3 Spring Summer Fall NURS 8314 Doctoral Research Practicum 2 NURS 9000 Doctoral Dissertation 6 NURS 9000 Doctoral Dissertation 6 Elective 3 Elective 3 Total 8 Total 6 Total 6 3 Years 9
PhD Curriculum Part-Time | Post-MSN Sample Plan of Study YEAR 1 Spring Fall NURS 8111 Philosophy of Science 3 NURS 8113 Health Equity Research 3 NURS 8112 Middle Range Theories in Nursing and Health Equity 3 PUBH 7150 Biostatistical Methods I 3 Total 6 Total 6 YEAR 2 Spring Fall NURS 8211 Qualitative Methods 3 NURS 8213 Quantitative Methods 3 PUBH 7160 Social and Behavioral Science Principles 3 NURS 8311 Doctoral Research Seminar I 3 Total 6 Total 6 YEAR 3 Spring Fall NURS 8312 Doctoral Research Seminar II 3 EDPR 8541 Statistical Methods & Apps in Education 3 Elective 3 ICL 8003 Curriculum Design and Evaluation 3 NURS 8313 Responsible Conduct of Research 1 Total 6 Total 7 YEAR 4 Spring Fall NURS 8314 Doctoral Research Practicum 2 NURS 9000 Doctoral Dissertation 3 Elective 3 Elective 3 Elective 3 Total 8 Total 6 YEAR 5 Spring Fall NURS 9000 Doctoral Dissertation 6 NURS 9000 Doctoral Dissertation 3 Total 6 Total 3 5 Years 10
PhD Curriculum Part-Time | Post-DNP* Sample Plan of Study YEAR 1 Spring Fall NURS 8111 Philosophy of Science 3 NURS 8113 Health Equity Research 3 NURS 8112 Middle Range Theories in Nursing and Health Equity 3 PUBH 7150 Biostatistical Methods I 3 Total 6 Total 6 YEAR 2 Spring Fall NURS 8211 Qualitative Methods 3 NURS 8213 Quantitative Methods 3 PUBH 7160 Social and Behavioral Science Principles 3 NURS 8311 Doctoral Research Seminar I 3 Total 6 Total 6 YEAR 3 Spring Fall NURS 8312 Doctoral Research Seminar II 3 EDPR 8541 Statistical Methods & Apps in Education 3 Elective 3 ICL 8003 Curriculum Design and Evaluation 3 Total 6 Total 6 YEAR 4 Spring Fall NURS 8314 Doctoral Research Practicum 2 NURS 9000 Doctoral Dissertation 6 Elective 3 NURS 8313 Responsible Conduct of Research 1 Total 6 Total 6 YEAR 5 Spring Fall NURS 9000 Doctoral Dissertation 6 Total 6 5 Years *Sample templates only, plan will be tailored for the student 11


12
Mission
To provide accessible and innovative higher education preparing leaders who promote health of the global community through excellent teaching, rigorous research and collaborative practice/service.
Vision
To create a center of excellence where education, research/scholarship, practice and partnerships integrate to advance nursing science and promote the health of the global community.
Strategic Goals
1. Advance Nursing Science
2. Student Success
3. Diversity and Inclusion
4. Innovative and High-Quality Academic Programs
5. Partnerships from Local to Global
13




For more information on the PhD in Nursing program, call 901.678.2003 or email uofmnursing@memphis.edu. 2502 Community Health Building Memphis, TN 38152 memphis.edu/nursing Preparing Leaders. Promoting Health. @UofMNursing @uofmnursing uofmemphis-nursing MemphisLCON